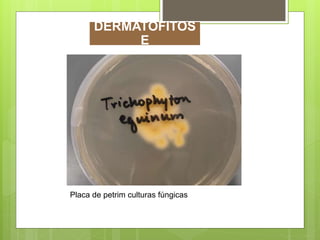
Placa de petrim culturas fúngicas
DERMATOFITOS
E

O documento discute três condições dermatológicas comuns em equinos: dermatofitose, dermatofilose e feridas. A dermatofitose é causada por fungos dermatófitos e causa lesões de pele. A dermatofilose é causada pela bactéria Dermatophilus congolensis e causa epidermite. As feridas podem ser classificadas como superficiais, profundas ou perfurantes e requerem tratamento e cuidados para cicatrização adequada.